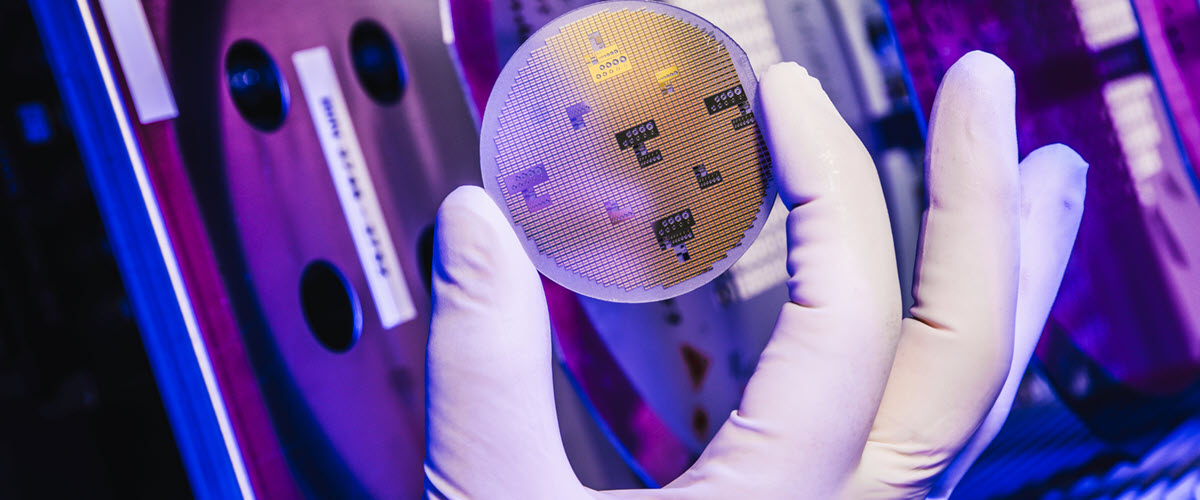

企业档案详细>>
- 普通商家认证商家
- 欧司朗光电半导体(中国)有限公司
- 经营模式:配套件供应商
- 所在地区:中国 江苏省 无锡市
产品分类全部>>
暂无分类
友情链接更多>>
暂无信息.
联系方式详细>>
公司简介详细>>
欧司朗(OSRAM)是世界领先的两大光电元件制造商之一,公司成立于1919年7月,总部位于德国慕尼黑,在全球拥有约39,000名员工,2013年7月,欧司朗在德国法兰克社福上市。
欧司朗光电半导体——半导体领域的创新推动者
无论是在技术研发领域,还是在优质产品制造方面,欧司朗光电半导体都是当之无愧的“标兵”。近四十年来,这家高科技公司一直致力于不断研发技术领先的新产品,为照明、可视化和传感器技术领域设立了多项国际标准。
欧司朗光电半导体的专业范畴从半导体基础技术一直延伸到个人客户应用,为传感器技术、激光系统等诸多领域打造最优质的解决方案。产品组合包括面向汽车照明、普通照明等应用的高性能发光二极管 (LED)、指示灯用微型 LED 以及红外发光二极管 (IRED)、半导体激光器和检测器。作为全球参与者,欧司朗光电半导体立足于多年来打下的坚实专业基础,全力为客户提供专业、全面的支持。
它专注于推动未来发展,多年来积极参与高端技术合作,与商界和院校均保持着密切的合作关系。此外,它非常重视公司内部的持续发展,已经孵化出许多创新项目,产品组合也得到了优化。所有这些,使得欧司朗光电半导体已经成为当今全球光电半导体市场的重要参与者。
公司新闻更多>>
- ams OSRAM 和Luxonis合作开发机器人的3D视觉2022-02-07 10:55

粤公网安备 44010602004352号